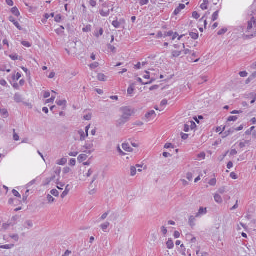
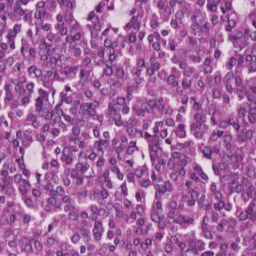
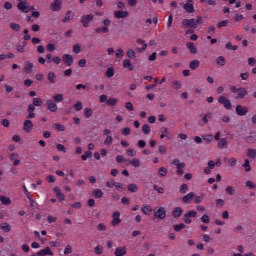

The cancer prognosis on gigapixel Whole-Slide Images (WSIs) has always been a challenging task. To further enhance WSI visual representations, existing methods have explored image pyramids, instead of single-resolution images, in WSIs. In spite of this, they still face two major problems: high computational cost and the unnoticed semantical gap in multi-resolution feature fusion. To tackle these problems, this paper proposes to efficiently exploit WSI pyramids from a new perspective, the dual-stream network with cross-attention (DSCA). Our key idea is to utilize two sub-streams to process the WSI patches with two resolutions, where a square pooling is devised in a high-resolution stream to significantly reduce computational costs, and a cross-attention-based method is proposed to properly handle the fusion of dual-stream features. We validate our DSCA on three publicly-available datasets with a total number of 3,101 WSIs from 1,911 patients. Our experiments and ablation studies verify that (i) the proposed DSCA could outperform existing state-of-the-art methods in cancer prognosis, by an average C-Index improvement of around 4.6%; (ii) our DSCA network is more efficient in computation -- it has more learnable parameters (6.31M vs. 860.18K) but less computational costs (2.51G vs. 4.94G), compared to a typical existing multi-resolution network. (iii) the key components of DSCA, dual-stream and cross-attention, indeed contribute to our model's performance, gaining an average C-Index rise of around 2.0% while maintaining a relatively-small computational load. Our DSCA could serve as an alternative and effective tool for WSI-based cancer prognosis.
翻译:千兆瓦全流图像上的癌症预测一直是一项艰巨的任务。 为了进一步加强西印度西印度西印度西印度西印度西印度西印度群岛的视觉表现, 现有方法探索了图像金字塔, 而不是单分辨率图像。 尽管如此, 它们仍面临两大问题: 计算成本高, 多分辨率特性融合中未察觉到的语义差距。 为了解决这些问题, 本文建议从新角度有效利用西印度西印度西印度群岛金字塔( 双流网络, 具有交叉关注的双流网络 ) 。 我们的主要想法是利用两个小渠道处理西印度西印度西印度西印度西印度西印度西印度西印度群岛的典型演示。 在高分辨率流中设计一个广场集合, 以大幅降低计算成本, 并提议一种基于交叉注意的方法来正确处理双流特征的融合。 我们用三个公开提供的数据集, 来自1,911个病人的3,101个模式的WSI, 以及双流网络的双流网络。 我们的实验和升级研究证实 (i) DSCA(i) 能够超越现有的状态- 数据流流流流流数据, 而多流化网络的递化网络的递化网络的系统化系统化为平均成本成本, 。